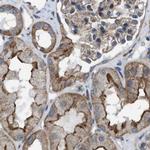
MYO18A Antibody in Immunohistochemistry (IHC)

Search
Invitrogen
MYO18A Polyclonal Antibody
{{$productOrderCtrl.translations['antibody.pdp.commerceCard.promotion.promotions']}}
{{$productOrderCtrl.translations['antibody.pdp.commerceCard.promotion.viewpromo']}}
{{$productOrderCtrl.translations['antibody.pdp.commerceCard.promotion.promocode']}}: {{promo.promoCode}} {{promo.promoTitle}} {{promo.promoDescription}}. {{$productOrderCtrl.translations['antibody.pdp.commerceCard.promotion.learnmore']}}
产品信息
PA5-54041
宿主/亚型
分类
类型
抗原
偶联物
形式
浓度
保存条件
运输条件
RRID
产品详细信息
Immunogen sequence: MEVMEMEVME ARLIRAAEIN GEVDDDDAGG EWRLKYERAV REVDFTKKRL QQEFEDKLEV EQQNKRQLER RLGDLQADSE ESQRALQQLK KKCQRLT
Highest antigen sequence identity to the following orthologs: Mouse - 95%, Rat - 94%.
靶标信息
MYO18A may link Golgi membranes to the cytoskeleton and participate in the tensile force required for vesicle budding from the Golgi. Thereby, may play a role in Golgi membrane trafficking and could indirectly give its flattened shape to the Golgi apparatus. Alternatively, in concert with LURAP1 and CDC42BPA/CDC42BPB, has been involved in modulating lamellar actomyosin retrograde flow that is crucial to cell protrusion and migration. May be involved in the maintenance of the stromal cell architectures required for cell to cell contact. Regulates trafficking, expression, and activation of innate immune receptors on macrophages. Plays a role to suppress inflammatory responsiveness of macrophages via a mechanism that modulates CD14 trafficking.
仅用于科研。不用于诊断过程。未经明确授权不得转售。